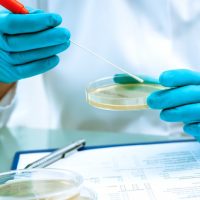

ჩვენს შესახებ
About Us
- არადისკრიმინაციული პირობები
- კონფიდენციალობა
- პოლიტიკა ხარისხის სფეროში
- განაცხადის ფორმა
- განაცხადის განხილვა
- სერტიფიკაციის სქემები
- ზედამხედველობა
- ხელშეკრულების ფორმა პროდუქტის ნებაყოფლობით სერტიფიცირების ჩატარებაზე
- საჩივრები და აპელაციები
- განაცხადი პროდუქტის სერტიფიცირების ჩატარებაზე
- ზედამხედველობის აქტის ფორმა
- პროდუქტის ნიმუშის აღების პროცედურა
- პროდუქტის სერტიფიკაციის ჩატარების პროცედურა
- სერტიფიკაციის ორგანოს დეკლარაციის პუნქტები მიუკერძოებლობის შესახებ
- წარმოების მდგომარეობის შეფასების ანალიზის აქტი


ინფორმაცია აკრედიტაციაზე
საგამოცდო ლაბორატორია
- შეფასების სტანდარტი: სსტ ისო/იეკ 17025:2017/2018-ის შესაბამისად
- აკრედიტაციის მოწმობის ნომერი: GAC-TL-0217
- აკრედიტაციის მოწმობის მოქმედების ვადა: 2029-ივლისი-21
პროდუქტის სერტიფიკაციის ორგანო
- შეფასების სტანდარტი: სსტ ისო/იეკ 17065:2012/2014
- აკრედიტაციის მოწმობის ნომერი: GAC-PRC-0022
- აკრედიტაციის მოწმობის მოქმედების ვადა: 2025-ნოემბერი-25

მისამართი
ქ. თბილისი, გუდამაყრის 4დ
ტელეფონი
0322 61 53 39
599 33 05 51
ელ-ფოსტა
temoexpert@yahoo.com
info@etalonilab.ge
